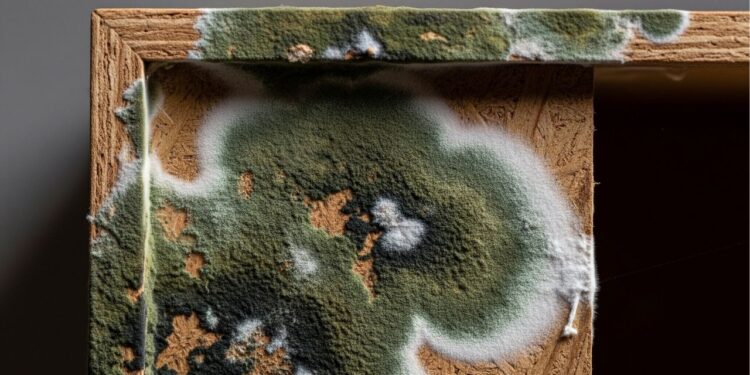
MDF com mofo? Veja o que fazer antes que o móvel estrague

Móveis de MDF são práticos e acessíveis, mas sofrem muito com a umidade. Esse problema pode causar deformações e reduzir a durabilidade do material.
Além disso, a presença de fungos é comum em ambientes fechados, comprometendo não só a estética dos móveis, mas também a saúde dos moradores.
Por que a umidade favorece a proliferação de fungos em móveis de MDF?
O MDF absorve água com facilidade, tornando-se um ambiente propício para mofo e bolor. Em locais mal ventilados, essa situação piora rapidamente.
Com o tempo, as colônias de fungos se instalam e podem atrair pragas que se alimentam de matéria orgânica, aumentando os riscos domésticos.
“A umidade excessiva cria microambientes ideais para o desenvolvimento de fungos e ácaros, exigindo medidas preventivas para reduzir riscos sanitários”, afirma William H. Robinson, entomólogo urbano, conforme ROBINSON, William H. Urban Insects and Arachnids. Cambridge: Cambridge University Press, 2005. p. 212.

Selantes impermeabilizantes aumentam a resistência do MDF
Aplicar produtos impermeabilizantes ajuda a criar uma barreira protetora contra a umidade. Essa etapa é fundamental em móveis de cozinhas e banheiros.
- Seladores acrílicos evitam a absorção de água
- Vernizes específicos reforçam a camada protetora
- Óleos de acabamento naturais aumentam a durabilidade
Esse cuidado simples reduz o risco de inchaço, rachaduras e proliferação de mofo nos móveis.
Boa ventilação reduz riscos de mofo em armários
A circulação de ar é essencial para manter o MDF livre de umidade. Armários fechados acumulam vapor e favorecem fungos.
- Evite encostar móveis diretamente nas paredes
- Use aberturas ou grelhas de ventilação
- Coloque desumidificadores em pontos estratégicos
Essas medidas ajudam a manter o ar seco e prolongam a vida útil do material em ambientes internos.
Limpeza frequente previne pragas e contaminações
A higienização regular evita que fungos se espalhem e serve como barreira contra insetos que se alimentam de matéria orgânica.
- Panos secos retiram excesso de poeira e umidade
- Soluções antifúngicas leves inibem o bolor
- Produtos neutros preservam a integridade do MDF
A limpeza preventiva reduz também a presença de alérgenos que afetam a saúde respiratória em ambientes domésticos.
“Ambientes internos úmidos favorecem a proliferação de fungos, aumentando a incidência de insetos sinantrópicos, como baratas e moscas”, alerta a Organização Mundial da Saúde, conforme WHO. Vector Control: Methods for Use by Individuals and Communities. Geneva: World Health Organization, 1997. p. 95.

Quais cuidados finais garantem móveis de MDF mais duráveis?
Com pequenas adaptações, é possível prolongar a vida dos móveis de MDF e evitar problemas de saúde causados por fungos.
- Escolha móveis bem acabados e selados de fábrica
- Evite exposição direta à água e vapor
- Realize inspeções periódicas para identificar sinais de fungos
Esses cuidados criam um ambiente mais seguro e aumentam a durabilidade do mobiliário.
Perguntas Frequentes
Posso usar produtos caseiros para proteger MDF da umidade?
Sim, alguns produtos caseiros como óleo mineral e cera podem ajudar, mas eles não substituem o uso de seladores e impermeabilizantes adequados.
Como saber se o MDF já foi afetado por fungos?
Sinais comuns incluem manchas escuras, odor de mofo e pequenas bolhas ou deformações na superfície do móvel.
Desumidificadores realmente funcionam contra mofo em móveis?
Sim, eles reduzem a umidade do ar e dificultam o desenvolvimento de fungos, sendo muito eficazes em ambientes fechados.
Cuidar dos móveis de MDF contra umidade e fungos não só mantém a estética, mas também garante mais saúde e durabilidade para o lar.
Veja também: O melhor truque para manter os móveis livres de poeira por dias